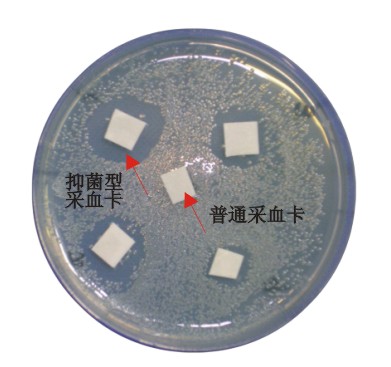

產(chǎn)品介紹:
抑菌型DNA存儲(chǔ)卡(DNA血樣采集卡)是一種以植物纖維為載體用于存儲(chǔ)DNA的新型介質(zhì),專(zhuān)為室溫下對(duì)各種生物體液(如血液、精液、唾液)、細(xì)胞培養(yǎng)液、微生物、植物組織和病毒等樣品進(jìn)行收集、運(yùn)輸和存儲(chǔ)而設(shè)計(jì)。通過(guò)獨(dú)特的配方和生產(chǎn)工藝使該產(chǎn)品同時(shí)具有了蛋白質(zhì)變性、細(xì)胞膜破裂、DNA吸附固定以及抑制細(xì)菌生長(zhǎng)之功能,從而保證目標(biāo)DNA在該存儲(chǔ)卡上存儲(chǔ)多年也不降低PCR效率,并且由于蛋白質(zhì)的變性使得生物樣品中的致病微生物或病毒喪失活性,避免了對(duì)操作人員的污染危險(xiǎn),同時(shí)也保證了長(zhǎng)途運(yùn)輸?shù)陌踩?/span>
產(chǎn)品特點(diǎn):
1、對(duì)樣品中致病微生物或病毒滅活,避免對(duì)操作人員的污染。
2、DNA樣品可以長(zhǎng)期室溫下保存,無(wú)需冷藏,大幅度降低DNA保存成本。
3、適用于室溫下長(zhǎng)途運(yùn)輸或者郵寄DNA樣本。
4、一個(gè)樣本可以為多種目標(biāo)DNA檢測(cè)使用,并且可以多次使用,便于復(fù)查、復(fù)檢。
應(yīng)用范圍:
DNA的采集,存儲(chǔ)和運(yùn)輸:DNA存儲(chǔ)卡可以用于法醫(yī)學(xué)和親子鑒定用建庫(kù)樣品DNA提取及PCR操作,并通過(guò)使用自動(dòng)化提取DNA的儀器,建立一種簡(jiǎn)單、易于操作的DNA自動(dòng)化提取程序。特別對(duì)于高危人群的取血過(guò)程中,能夠大幅度降低檢驗(yàn)對(duì)所需血樣量的需求,同時(shí)對(duì)傳染性的病菌或者病毒進(jìn)行滅活,避免對(duì)操作人員的污染,加強(qiáng)對(duì)于采血人員的保護(hù)。另外DNA存儲(chǔ)卡還可以用于犯罪現(xiàn)場(chǎng)DNA提取,野外采集植物、動(dòng)物DNA樣本等。

血樣采集卡授權(quán)發(fā)明專(zhuān)利 抑菌型血樣采集卡,可以 利用Identifiler Plus試劑盒擴(kuò)增保存在
看到明顯的抑菌環(huán) 鼎偵血樣采集卡上的一個(gè)樣本
鼎偵系列血樣采集卡
| 產(chǎn)品名稱(chēng) | 貨號(hào) | 型號(hào) | 包裝形式 | 產(chǎn)品尺寸 | 數(shù)量 |
是否可以 |
備注 |
| 血樣采集卡 | NOVE1010 | 專(zhuān)業(yè)型 | 單卡 | 38mm*100mm | 100份 | 是 | 進(jìn)口基材 |
|
血樣采集卡套裝 |
NOVE1011 | 專(zhuān)業(yè)型 |
單卡、酒精棉簽、 |
38mm*100mm | 100套 | 是 | 進(jìn)口基材 |
| 血樣采集卡 | TANA0810 | 抑菌型 | 單卡 | 50mm*75mm | 100份 | 是 | 國(guó)產(chǎn)基材 |
|
血樣采集卡套裝 |
TANA0811 | 抑菌型 |
單卡、酒精棉簽、 |
50mm*75mm | 100套 | 是 | 國(guó)產(chǎn)基材 |
| 血樣采集卡 | TANA1010 | 旗艦抑菌型 | 單卡 | 50mm*75mm | 100份 | 是 | 進(jìn)口基材 |
|
血樣采集卡套裝 |
TANA1011 | 旗艦抑菌型 |
單卡、酒精棉簽、 |
50mm*75mm | 100套 | 是 | 進(jìn)口基材 |
| DNA存儲(chǔ)卡 | TANA1210 | 旗艦抑菌型 | 單卡 | 38mm*75mm | 100份 | 是 | 進(jìn)口基材 |
|
DNA存儲(chǔ)卡套裝 |
TANA1211 | 旗艦抑菌型 |
單卡、酒精棉簽、 |
38mm*75mm | 100套 | 是 | 進(jìn)口基材 |
XQ系列血樣采集卡
| 產(chǎn)品名稱(chēng) | 貨號(hào) | 型號(hào) | 包裝形式 | 產(chǎn)品尺寸 | 數(shù)量 |
是否可以 |
備注 |
|
血樣采集卡 |
XQ121201 |
標(biāo)準(zhǔn)型 |
單卡 |
38mm*100mm |
100份 |
是 |
國(guó)產(chǎn)基材 |
|
血樣采集卡套裝 |
XQ121202 | 標(biāo)準(zhǔn)型 |
單卡、酒精棉簽、 |
38mm*100mm | 100套 | 是 | 國(guó)產(chǎn)基材 |
|
血樣采集卡 |
XQ130101 | 經(jīng)典型 | 單卡 | 50mm*75mm | 100份 | 是 | 國(guó)產(chǎn)基材 |
|
血樣采集卡套裝 |
XQ130202 | 經(jīng)典型 |
單卡、酒精棉簽、 |
50mm*75mm | 100套 | 是 | 國(guó)產(chǎn)基材 |
上一篇:沒(méi)有了
下一篇:沒(méi)有了
版權(quán)所有 天津諾維萊博科技有限公司 備案號(hào):津ICP備19001986號(hào)-1 Copyright 2009 - 2019. All Rights Reserved